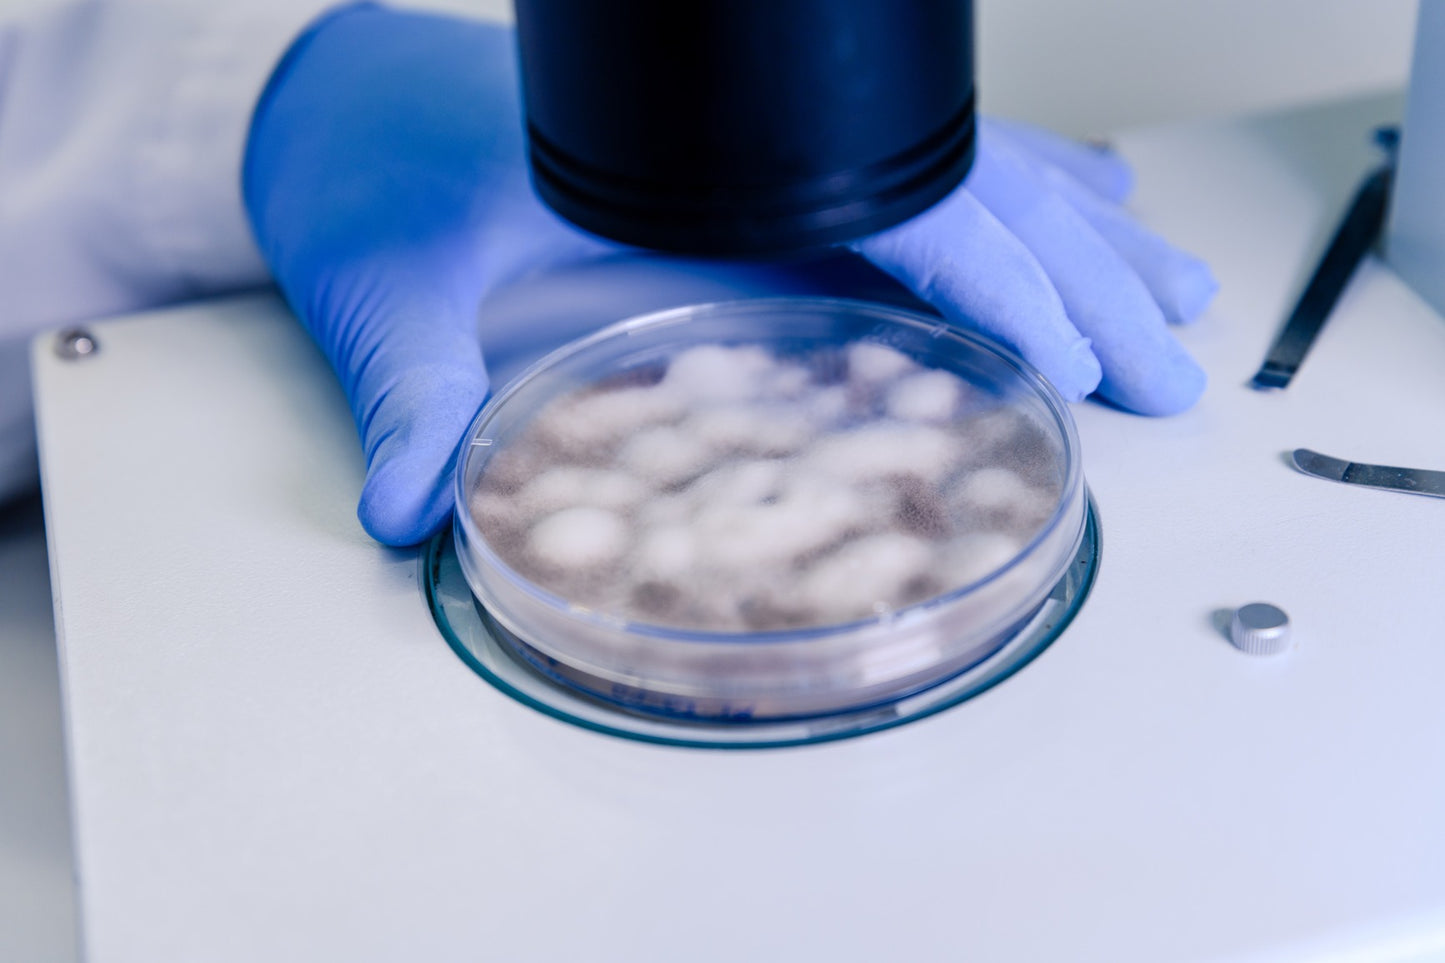
Hericium abietis

1
/
de
1
My Store
Hericium abietis
Hericium abietis
Prix habituel
CHF 40.00
Prix habituel
Prix promotionnel
CHF 40.00
Prix unitaire
/
par
Taxes incluses.
Frais d'expédition calculés à l'étape de paiement.
Impossible de charger la disponibilité du service de retrait
Cette variété de crinière de lion est spécifique aux conifères, ce qui la rend unique pour les cultivateurs cherchant des champignons avec des caractéristiques distinctes.
- Description : Hericium abietis, adapté aux substrats spécifiques de conifères, avec une texture intéressante et un goût délicat.
- Utilisation : Idéal pour les plats gastronomiques et les applications bien-être.
Prix : CHF 30.-- pour un verre pétri en verre avec le mycélium colonisé sur agar.
Share